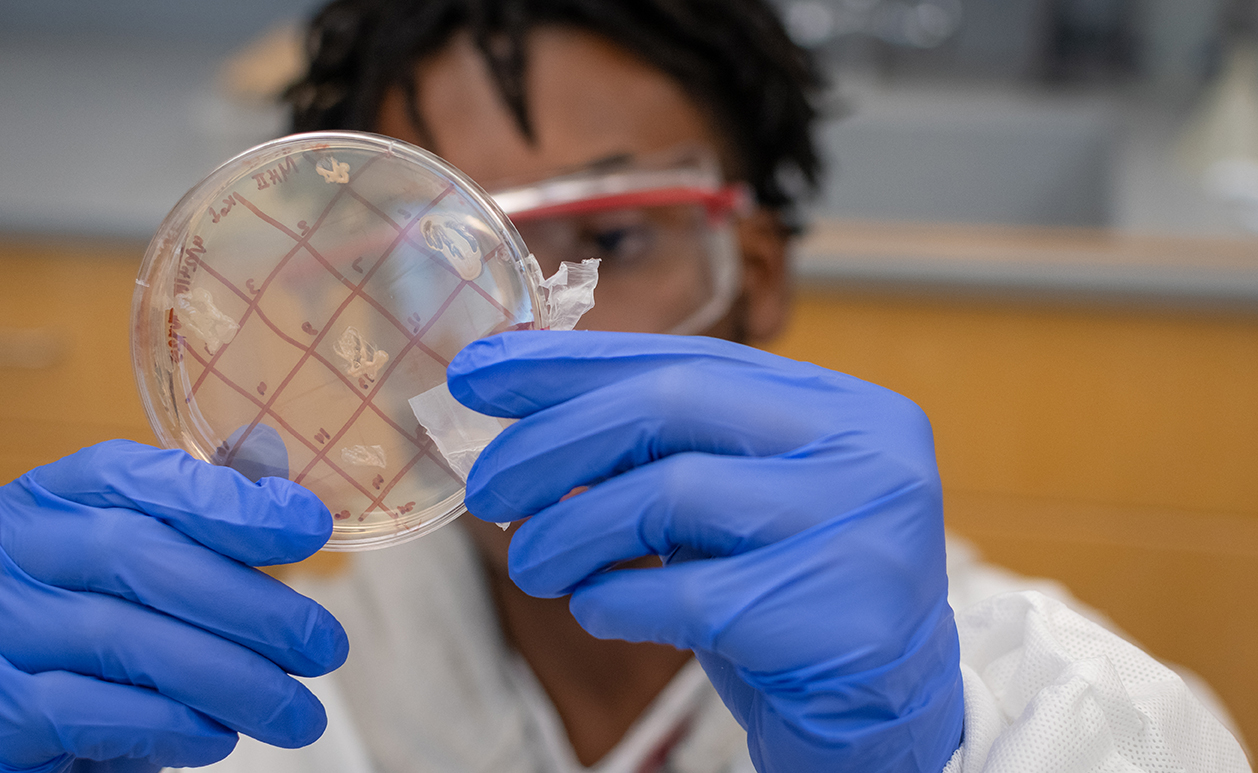
Clark students dig deep for solutions to the superbug problem

Major in Biology
-
Biology major Alaina Tabani ’20 seeks a career path that puts patients first
Internships, lab work, and mentors help shape her Clark experience
-
Biology researcher Lucas Brandao ’20 splits time between Clark and Yale
Student investigates genetic mutation linked to autism, ADHD
-
Clark students dig deep for solutions to the superbug problem
Tiny Earth lab is a hunt for the origins of new antibiotics
-
Clark biologist investigates a microscopic arms race waged in the ocean
Research uncovers uneasy relationship between viruses and bacteria
-
National Academy of Sciences publishes Clark worm study
Physics research may have future medical applications
-
As both a biologist and angler, Quincy Milton III is at home in the water
Clark student-athlete brings his fly-fishing skills to area rivers
-
Clark students get their hands dirty with ant research
Biologist: The insects are critical protectors of the ecosystem
-
Alumni offer Clark students tips on finding careers that promote ‘scientific fearlessness’
Session outlines ways to secure STEM jobs in a competitive marketplace
-
Former Clark diving captain is still taking the plunge
Steve Castiglione ’18 entertains audiences at Colorado resort
-
Clark graduates launch careers in Massachusetts – the country’s No. 1 job market
Students put their skills to work, from State Street to Dana-Farber